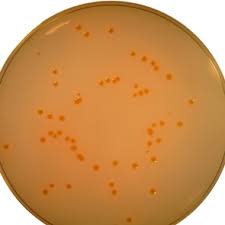

Home
SRL was established in the year 1975 to meet the growing demand of Research Chemicals in India and neighbouring countries. Under leadership of Chairman and Managing Director, Mr. S.K. Agarwal, the Company has completed more than 4 decades of manufacturing highly complex and international quality Reagents & Biochemicals in India. at a time when no other Indian company had the know-how or the technical expertise to perform the complex reactions required for manufacturing very high purity biochemicals. Today the Company manufactures and markets a product range of about 5000 products in different grades, product segments and and various standard packing sizes. We also offer these sophisticated and high purity chemicals in bulk and semi-bulk packs to the R&D and production units of various industries, universities & research institutions for their larger requirements.
All products are classified mainly in 5 categories,
1. General Laboratory Chemicals & Solvents
2. Bioreagents, Biochemicals & Specialty Fine Chemicals
3. Nanotechnology Products
4. Dehydrated Culture Media, Biological Ingredients, Media Supplements, Chromogenic Media & Media Kits
5. BioLit™ range of DNA and Protein tools
We are ISO, FDA, GMP & CE certified for our Management Systems and Product Range for use in the R&D and manufacture of Analytical Quality Control, Research, Pharmaceuticals, Diagnostic Kits & Vaccines.
Production process:
For our chemical processes, we process and synthesise all products in Glass-lined, SS or PTFE vessels to keep the products free from ionic, metallic or other contaminants depending on the products which are being processed. The plants handling these complex chemical and biochemical products are FDA approved and operate using cGMP guidelines.
SRL has pioneered in India the production of several reagents like Agaroses, Methylene Bisacrylamides, Sodium Lauryl Sulphates, Gel Filtration Media, Electrophoresis Reagents, Atomic Absorption Standard Solutions (AAS), Sodium Biphenyl and many other speciality Reagents and Biochemicals used in research and in industry.
Our highly trained technical staff has gained proficiency in synthesising & purification of several Aromatic Ketones, Tetraammonium Hydroxides, Alkyl Sulphonic Acids Sodium Salts, Acid Chlorides, Alkyl Halides, Phosphate Esters, Mutagenic Agents, Scintillating Agents, Spectral & HPLC Solvents, Reagents for Electrophoresis & Molecular Biology, Biological Buffers, Enzyme Substrates, Various Reagents for spot tests and other specialties.
At our production plants, personnel safety and avoidance of hazards are our primary concern. The plant undergoes semi-annual shut-downs and maintainance which make sure that all Unit operations and Utilities are operating at optimum efficiences.
Post-production activities such as drying, pelletizing, handling and packing are done in completely climate & humidity controlled environments. Extreme care is taken at this stage of the final product packaging & storage.
For our microbiological culture media, we require very special conditions of manufacure which are all done in CE Certified facilities. The entire production facility is maintained as a Strictly Restricted and a Class 10,000 Area and the production is done strictly in SS vessels which have been sterilized.
All our media manufactured using state-of-the-art technology thereby preventing any possible contamination of the product and maintaining the nutritional and restrictive properties of the final product. It is perhaps due to this dedication and obsessiveness to quality, that our products are the first-preference media to more than half the research done within the country and in the Asian continent.
For SRL dehydrated culture media range, the use of the highest quality of raw materials, especially the biologicals, enable our media to give standard colony sizes, colony count and optimum growth parameters along with the specified colony characteristics. The media and supplements give excellent results when tested in diagnostic and pharmaceutical environments due to the manufacture as per cGMP & WHO Standards. Our highly trained and experienced production team ensures that the products we manufacture give the desired consistent results batch after batch.
Products & Services
Highest quality standards are achieved through the implementations of latest technology, decades of experience and everlasting moral values , which have helped us to retain our customers as well as multiply them.